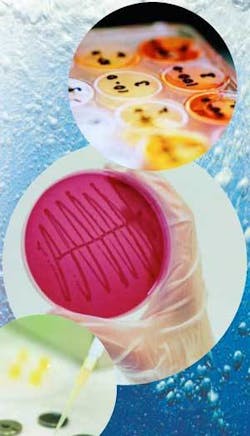
Th 0705wwiworking01 Th 0705wwiworking01

Working to meet the Water Framework Directive
Considering the plethora of recent reports assessing future impacts of climate change on water resources, concerns raised and measures promoted to address them by the European Union Water Framework Directive are more imperative than ever.
European Union (EU) legislation detailing the Water Framework Directive (WFD) came into force in December 2003, providing a clear framework for the protection, improvement and sustainable use of water across Europe. Among those working on a development programme to help organisations meet the analytical requirements of the new directive, Severn Trent Laboratories (STL) is now able to offer the majority of analysis. The company is working closely with customers to ensure its analytical package meets the redefined legislative requirements.
The main objectives of the directive, which has since been transposed into UK law, are to:
- Enhance the status and prevent further deterioration of aquatic ecosystems and associated wetlands - there’s a requirement for nearly all-inland and coastal waters to achieve ‘good status’ by 2015
- Promote sustainable use of water
- Reduce pollution of water, especially by ‘priority’ and ‘priority hazardous’ substances
- Lessen the effects of floods and droughts
Standards
Proposed Environmental Quality Standards (EQS), outlined under the directive, will be rated by the following classification system to assess the state of the water environment.
Surface water bodies will be classified by:
- Ecological status - five classes (high/good/moderate/poor/bad)
- Chemical status - two classes (pass/fail)
With a separate classification system for groundwater by: - Groundwater quantitative status - two classes (pass/fail)
- Groundwater chemical status - two classes (pass/fail)
These standards define the quantity of a pollutant that’s safe to be present in the water environment without causing harm to the ecology, and as such, form part of the monitoring programme.
There are three types of environmental standards being developed for the WFD:
•Priority Substances and Priority Hazardous Substances - Compliance with the Priority Substance standards will be used to define ‘good chemical status’. Priority substances are classified as being harmful and Priority Hazardous Substances extremely harmful to human health and the environment. As a consequence their concentration must be limited.
Specific Pollutants - these are part of the classification of good ecological status and are pollutants that are released in significant quantities into water bodies in a particular country.
•Physio-Chemical Pollutants - these are part of the classification of good ecological status and are mainly naturally occurring, such as temperature and nutrients.
Priorities
In 2006, the EU put forward proposals for a “Daughter” Directive that will introduce the Environmental Quality Standards for Priority and Priority Hazardous Substances. Currently under negotiation, the proposal is intended to replace current “Daughter” Directives relating to chemical pollution of waters that detail emission limit values and Environmental Quality Objectives.
The WFD defines the list of 33 Priority Substances, established in 2001. The new proposal covers 41 chemical substances or groups of substances, including the 33 priority substances and 8 other substances. Thirteen of the priority substances are classed as “Hazardous”. Within the proposal is a table indicating Environmental Quality Standards (EQS) for Priority Substances and certain other pollutants (Annex 1) as well as a list of priority hazardous substances in the field of water policy (Annex 2).
STL’s development programme, scheduled to be completed in time for the start of the monitoring programme later in the year, is continuing to ensure compliance with the EQS and Maximum Admissible Concentrations (MAC) within an available proposal table.
Why does it need protection?
The importance of water for life and as a component of the global ecosystem is becoming increasingly clear. It is a resource that not only provides basic needs for the human population and is the key to development in particular to generate and sustain wealth through agriculture, commercial fishing, power generation, industry, transport and tourism, but water is vital for all global ecosystems. However, the facts show that we face a global water crisis.
At first glance, this does not appear to apply to Europe’s water. After all, the continent faces no overall water shortages. However, Europe’s water quality and Europe’s water management is, in fact, far from satisfactory.
Key Facts about the Global Water Situation
- Less than 1% of the planet’s water is available for human consumption.
- More than 1.2 billion people have no access to save drinking water.
Key Facts about the European Water Situation
- 20% of all surface water in the European Union is seriously threatened with pollution.
- Groundwater supplies around 65% of all Europe’s drinking water.
- 60% of European cities overexploit their groundwater resources.
- 50% of wetlands have “endangered status” due to groundwater over-exploitation.
- The area of irrigated land in Southern Europe has increased by20% since 1985.
Given the numerous, and increasing, pressures on our water resources, it is vital that effective legislative instruments address the problems effectively and help secure these resources for future generations.
The Water Framework Directive expands the scope of water protection to all waters and sets a clear objectives that “good status” must be achieved for all European waters by 2015 and that sustainable water use is ensured throughout Europe.
European Commission brochure, “Water Is Life - Water Framework Directive”, www.eurogeographics.org/eng/07_links_euin_WFD.asp
EC assesses WFD implementation
The European Commission adopted a communication toward sustainable water management in the EU giving a sometimes bleak snapshot of the status of Water Framework Directive (WFD) implementation, according to an EMWIS e-Flash from the Euro-Mediterranean Water Information System. This assessment, presented at the EU Water Conference on 22-23 March in Brussels, is based on official reporting from EU member states. It focuses on three elements of the WFD to be implemented before 2007: transposition into national law, administrative arrangements and environmental & economical analysis. Key conclusions are that implementation of the WFD is well advanced with some positive examples, significant shortcomings identified require more efforts - but time remains to achieve objectives by 2015.
Most EU states haven’t properly transcribed the WFD into national legislation, assessed water management costs or earmarked cash for investments, noted EC environment commissioner Stavros Dimas. A scorecard unveiled at the Brussels event singles out Italy, Greece, Finland, Sweden, France, Spain, Denmark, Belgium, Poland, Latvia and Malta as lagging in areas. He criticized 12 new EU states for failure to allocate funds for €35 billion in water management projects identified as necessary to boost water quality. Dimas said the WFD and upcoming Marine Directive are tools member states must implement to deal with increasing challenges of climate change, including flooding and drought.
The commissioner also touted the recent launch of the Water Information System for Europe (WISE) web portal at: water.europa.eu. Other EC communication on water scarcity, as well as a green paper on how to adapt wider EU energy, transportation and industry policy to water and climate change issues, will be addressed this summer. For more, including presentations at the EU Water Conference, see: www.emwis.net/initiatives/dce